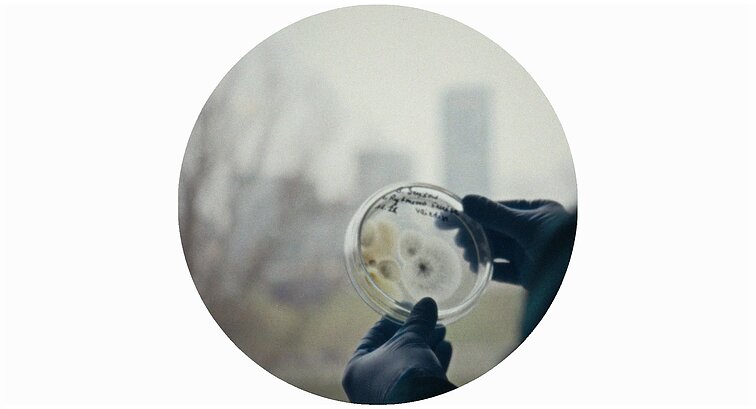
„Dulkės, kaulai ir stebuklai“

Vėlyvoje paauglystėje man didelį įspūdį padarė režisieriaus Peterio Greenaway‘aus kalba „Svarbiausias kino raidos rezultatas“. Kalbėjo jis apie kiną ribojančias tironijas, tarp jų – ir rėmo tironiją. „Kodėl, pradedant nuo Renesanso, menas pasirinko vieną geometrinę formą – keturkampį? <...> Kodėl mes taip prie jos prisirišę <...>?“ – klausė P. Greenaway‘us.
Prisiminiau šį tekstą žiūrėdama Amsterdamo ir Talino kino festivaliuose apdovanotą Aistės Žegulytės dokumentinį filmą „Dulkės, kaulai ir stebuklai“ („Holy Destructors“), kuriame didžioji dalis kadrų įrėminti apskritime ir tik kartais grįžta prie mūsų akiai įprasto stačiakampio.
Keičiant formatus perprogramuojamas žvilgsnis. Žmonės ir jų trumpalaikiai darbeliai filme fiksuojami apskritime, kuris tradiciškai kaip tik siejamas su amžinybe, tarsi žvelgtume pro mikroskopą į laboratorinėje lėkštėje vykstančius procesus. Ir tik mikrogrybai mus grąžina į klasikinį formatą. Tai jie, abstrakcijomis sužydintys šventieji destruktoriai, veikia amžinybės kategorijoje ir turi teisę į stačiakampį.

Žegulytė kartu su operatoriumi Vytautu Katkumi nėra pirmieji, kadrą fiksavę apskritime. Galime prisiminti, pavyzdžiui, Feng Xiaogango filmą „Aš nesu ponia Bovari“ („I Am Not Madame Bovary“, 2016 m.). Tačiau būtent jis yra neblogas įrodymas, kaip radikalus formos sprendimas nebūtinai kuria kitokią žiūrėjimo patirtį – vien susprausti kadro į apskritimą nepakanka.
Filme „Dulkės, kaulai ir stebuklai“ toks ėjimas pagrindžiamas konceptualiai ir todėl virsta ne tik estetiniu, bet ir prasmės kūrimo įrankiu. Kartu jis kviečia iš esmės permąstyti kadrą kaip struktūrinį kino vienetą ir tai, ką laikome jo konstantomis.
Tai svarbus kūrybinis judesys, atliepiantis filmo temą. Jei reikėtų įvardyti, apie ką yra „Dulkės, kaulai ir stebuklai“, sakyčiau, kad apie laikinumą ir mūsų bergždžią siekį su juo galynėtis. Filme matome skirtingas to apraiškas: bandymą išsaugoti mirusiųjų palaikus, restauruoti paveikslus ir tirti pelėsio raizginius, kurie kėsinasi į trapų grožį ir prasmę.
Savo tema ir tonu filmas susišaukia su Žegulytės debiutu, 2018 m. pasirodžiusiu dokumentiniu filmu „Animus animalis“. Kaip gyvūnų iškamšos jame, taip mikrogrybai „Dulkėse, kauluose ir stebukluose“ tapo atspirties tašku svarstymams apie tai, ką reiškia žvelgti į pabaigą ir bandyti užkonservuoti laiką. Gretindama priešybes – šventą ir žemišką, gyvą ir mirusį, pakylėtą ir komišką – režisierė panardina mus į lėtą, takų laiką, sukurdama meditaciją apie mūsų pačių gyvenimo laikinumą.
Joje jungtys punktyriškos, nesaistomos naratyvinių ar geografinių konvencijų. Štai visą filmą leidę Lietuvoje – miestų požemiuose, mokslininkų laboratorijose, restauratorių dirbtuvėse, bažnyčiose – staiga esame perkeliami į Ispaniją, Velykų savaitės procesiją. Filmas netikėtai išsprūsta iš to, ką jau manėme esant jo rėmu. Bet tokiam kontrapunktui visai nesinori priešintis, juolab kad atpažįstame tuos pačius bendravardiklius.
Ir kaip aš, visai nereligingas žmogus, savo nuostabai susigraudinau stebėdama paveikslo bažnyčioje atidengimo sceną.
Turbūt pagrindiniu, visą filmą struktūruojančiu elementu (montažo režisierius – Danielius Kokanauskis) vis dėlto tampa ne mikrogrybai, kurie dažniau suveikia kaip amžinybės refrenas, bet religija, ieškanti būdų, formų, išraiškų artėti prie mums nepažinios amžinybės klausimų.
Čia svarbus ir kultūrinis, istorinis religijos paveldas, ir rituališkumas. Juk neatsitiktinai tiek rūpesčio kelia būtent vyskupų palaikai, restauruojamas Švč. Mergelės Marijos su Kūdikiu paveikslas, o į kadro apskritimą patenka sakralinės dailės pavyzdžiai, bažnyčios rožės vitražas, religinės apeigos. Sakraliniai motyvai, beje, vienu metu pasigirsta ir Gedimino Jakubkos garso takelyje, stebint augančius mikrogrybus ir taip darkart sukabinant šias dvi temas.
Kažkuriuo metu gali pradėti atrodyti, jog filmo ištarmė ima kartotis (čia būtų galima pasvarstyti ir apie deklaratyvoką sprendimą įrėminti filmą archyviniais kadrais, turbūt vienintelį mano akiai pasiūliusį per akivaizdžią interpretaciją). Bet pernelyg užsiliūliuoti filmo cikliškume neleidžia jautri ir gyva medžiaga, iš tiesų kažką giliai sukrutinanti.

Ryškiausiai atmintyje įstrigo, kaip pelėsio pūkeliai švelniai kutena Vladislovo Neveravičiaus „Šv. Marijos Magdalietės“ ausytę. Ir kaip aš, visai nereligingas žmogus, savo nuostabai susigraudinau stebėdama paveikslo bažnyčioje atidengimo sceną.
Greenaway‘us, prisimintas šios recenzijos pradžioje, toje pat prakalboje konstatavo kino mirtį. Esą kinas tapo nuobodus ir pats kasasi sau kapą, neperžengdamas įprastos kino kalbos rėmų ir pernelyg dažnai kliaudamasis žodžiu, o ne vaizdu. Greenaway‘aus pozicija, aišku, užaštrinta, dogmatiška, verta diskusijų. Bet pati jo teksto šerdis apie kino laisvės poreikį ir nuolatinį paieškos alkį nenustojo aktualumo.
„Dulkės, kaulai ir stebuklai“ yra ryškus pavyzdys, liudijantis, kiek daug gali drąsa nesikliauti jau nubraižytais žemėlapiais – būtent taip gimsta savitas režisūrinis braižas. Ir jei kam nors dar kilo abejonė, šis filmas kartu tampa įrodymu, kad kinas alive and kicking. Net tada, kai kalba apie mirtį.
Nepraleiskite svarbiausių kultūros naujienų ir gaukite jas kiekvieną penktadienį į savo elektroninio pašto dėžutę užsisakę LRT kultūros naujienlaiškį. Šio naujienlaiškio nenorėsite atsisakyti.


































